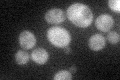
YLR412W
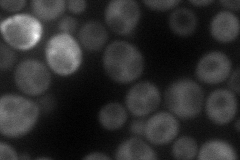
YLR412W
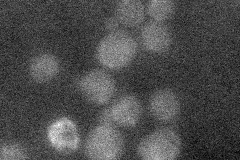
YLR412W
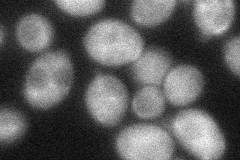
YLR412W
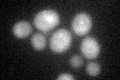
YLR412W
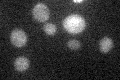
YLR412W

View description
Protein involved in microtubule-related processes, N-acetylation; GFP-fusion protein localizes to the cytoplasm and is induced in response to the DNA-damaging agent MMS; YLR412W is not an essential gene; similar to Arabidopsis SRR1 gene
Localization:
Intensity:
Fold change:
Significance:
-
C’ GFP library in SD
cytosol28.91 -
N' NOP1pr-GFP in SD

cytosol55.3073 -
N' TEF2pr-mCherry in SD
cytosol77.8918 -
N' NATIVEpr-GFP in SD
below threshold22.3789 -
N' TEF2pr-VC and Cyto-VN in SD
cytosol43.5664 -
C’ GFP library in SD+DTT
cytosol25.70.88No -
C’ GFP library in SD+H2O2

cytosol26.710.92No -
C’ GFP library in Starvation Media
cytosol23.730.82No -
C’ GFP library on the background of Pup2-DaMP

cytosol -
C’ GFP library on the background of CCT mutant

cytosol27.23390.941659No
